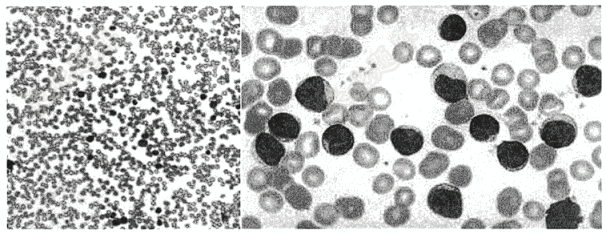

试题详情
- 单项选择题患者男,76岁。体检发现血常规异常。体格检查:体温36.5℃,颈部可触及花生仁大小淋巴结2枚,脾肋下2cm。实验室检查:血红蛋白125g/L,白细胞23.3×10⁹/L,血小板145×10⁹/L;血涂片中淋巴细胞占82%。骨髓细胞学检查如图所示:成熟淋巴细胞占62%。患者最可能的诊断是( )
A、恶性淋巴瘤
B、慢性淋巴细胞白血病
C、慢性再生障碍性贫血
D、急性淋巴细胞白血病
E、骨髓增生异常综合征
关注下方微信公众号,搜题查看答案

热门试题
- 患者男性,59岁,主因腹痛6小时就诊。查
- 请选出正确答案( )
- 患者男,59岁,咳嗽、咯血10余天。
- 下列心电图检查最可能的是( )
- 患者女,45岁,气促、发热1月余。午后低
- 请选出正确诊断( )
- 男,68岁。因“上腹痛1年,解黑便伴头晕
- 患者女,25岁。癫痫起病,MRI如图所示
- 男,35岁,突发意识障碍5天。图中所示脑
- 男性患儿,1岁。发现心杂音半年来诊,口唇
- 男性,55岁,头都摔伤3小时,头颅CT平
- 患者男,48岁,因头痛就诊,头颅MR如下
- 请选出正确诊断( )
- 请选出正确诊断( )
- 男性,49岁,发热一周( ) <
- 男,32岁,左侧腕关节包块( )
- 患者男,63岁,反复腹痛2月余
- 下列心电图检查最可能的是( )
- 下列心电图诊断最的是可能的是( )
- 患者男性,62岁。剧烈胸痛1.5小时。诊